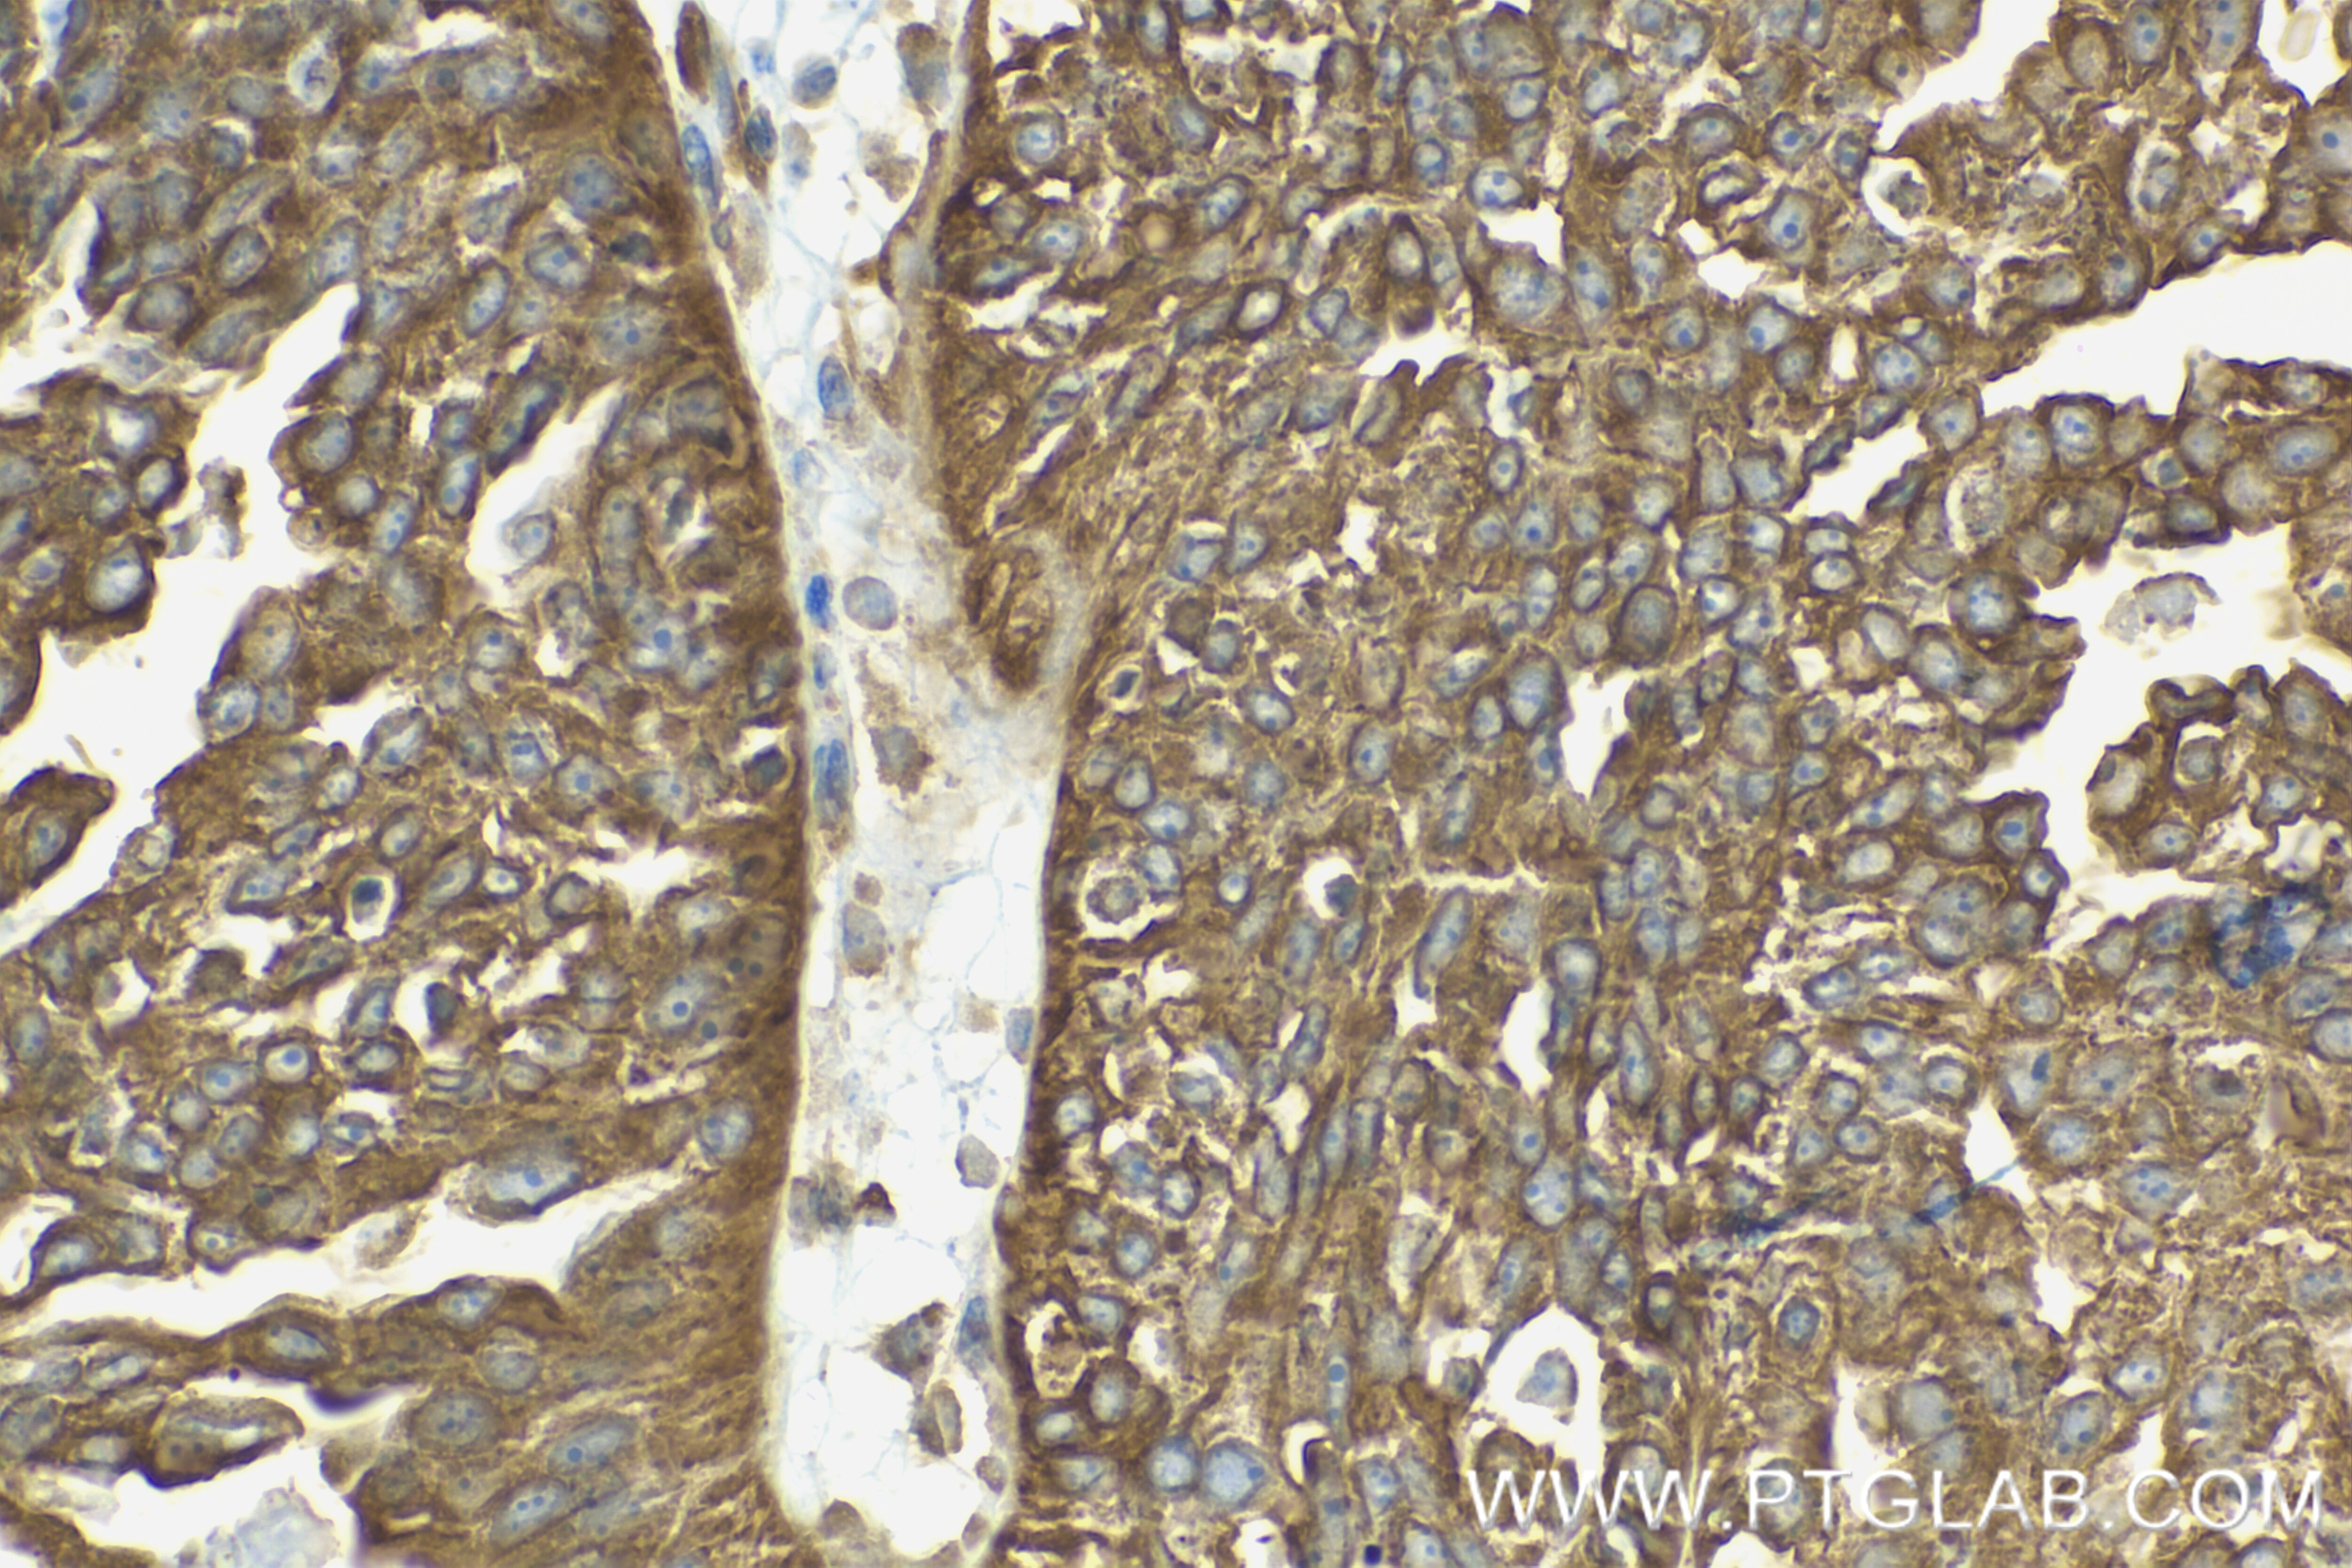

Product Information
85030-1-PBS targets PDE5A as part of a matched antibody pair:
MP01762-3: 85030-4-PBS capture and 85030-1-PBS detection (validated in Sandwich ELISA)
Unconjugated rabbit recombinant monoclonal antibody in PBS only (BSA and azide free) storage buffer at a concentration of 1 mg/mL, ready for conjugation. Created using Proteintech’s proprietary in-house recombinant technology. Recombinant production enables unrivalled batch-to-batch consistency, easy scale-up, and future security of supply.
This conjugation ready format makes antibodies ideal for use in many applications including: ELISAs, multiplex assays requiring matched pairs, mass cytometry, and multiplex imaging applications.Antibody use should be optimized by the end user for each application and assay.
| Tested Reactivity | human, mouse, rat |
| Host / Isotype | Rabbit / IgG |
| Class | Recombinant |
| Type | Antibody |
| Immunogen |
CatNo: Ag18779 Product name: Recombinant human PDE5A protein Source: e coli.-derived, PGEX-4T Tag: GST Domain: 321-482 aa of BC126233 Sequence: ETSLLENKRNQVLLDLASLIFEEQQSLEVILKKIAATIISFMQVQKCTIFIVDEDCSDSFSSVFHMECEELEKSSDTLTREHDANKINYMYAQYVKNTMEPLNIPDVSKDKRFPWTTENTGNVNQQCIRSLLCTPIKNGKKNKVIGVCQLVNKMEENTGKVK Predict reactive species |
| Full Name | phosphodiesterase 5A, cGMP-specific |
| Calculated Molecular Weight | 875 aa, 100 kDa |
| Observed Molecular Weight | 100 kDa |
| GenBank Accession Number | BC126233 |
| Gene Symbol | PDE5A |
| Gene ID (NCBI) | 8654 |
| Conjugate | Unconjugated |
| Form | Liquid |
| Purification Method | Protein A purification |
| UNIPROT ID | O76074 |
| Storage Buffer | PBS only, pH 7.3. |
| Storage Conditions | Store at -80°C. |
Background Information
PDE5A (cGMP-binding cGMP-specific phosphodiesterase) plays a role in signal transduction by regulating the intracellular concentration of cyclic nucleotides. This phosphodiesterase catalyzes the specific hydrolysis of cGMP to 5'-GMP. Through alternative splicing, the PDE5A gene produces three proteins (PDE5A1, PDE5A2, and PDE5A3) that differ in their N termini and range in mass from 89 to 105 kDa. (PMID: 25704994; 21215707). A second 70 kDa band was consistently observed in heart tissue that either reflected a splice variant or proteolytic fragment of PDE5A. (PMID: 15576651).